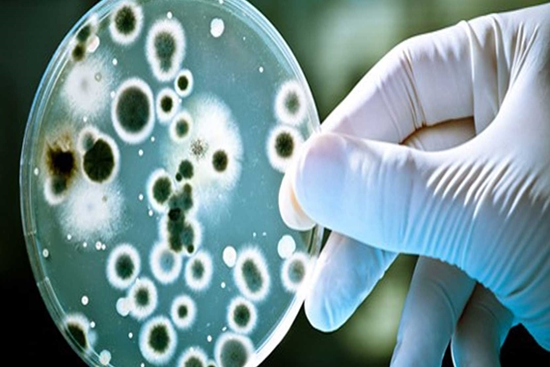

در فصل گرما مراقب تب مالت باشید/هشدارهایی برای مقابله با این بیماری
دکتر شبنم طهرانی متخصص بیماری های عفونی و عضو هیأت علمی گروه عفونی دانشگاه علوم پزشکی شهید بهشتی، گفت: بروسلوز (تب مالت) یکی از مهمترین بیماری های قابل انتقال از حیوان به انسان در سراسر دنیا می باشد.
دکتر شبنم طهرانی متخصص بیماری های عفونی و عضو هیأت علمی گروه عفونی دانشگاه علوم پزشکی شهید بهشتی، گفت: بروسلوز (تب مالت) یکی از مهمترین بیماری های قابل انتقال از حیوان به انسان در سراسر دنیا می باشد.
این بیماری درکشور ایران اندمیک بوده است و یکی از مسایل مهم بهداشتی به شمار می آید. بیماری در تمام فصول وجود دارد، اما درفصل بهار و تابستان همزمان با فصل زایش و شیردهی دامها بیشتر دیده میشود. بیماری در مناطق روستایی بیشتر از مناطق شهری میباشد که مرتبط با تماس با دام آلوده و استفاده از فرآوردههای لبنی غیرپاستوریزه در مناطق روستایی میباشد. وی در ادامه افزود: بروسلا (عامل تب مالت)، باکتری گرم منفی، غیر متحرک و داخل سلولی می باشد و در ریشهکنی بیماری در انسان فعالیت فاگوسیتوز سلولهای پلی مرفونوکلئر و منونوکلئر از جمله ماکروفاژها نقش اساسی دارد. سیر طبیعی بیماری تحت تاثیر فاکتورهای چون مقدار ارگانیسم تلقیح شده، قدرت بیماریزایی سویه باکتری، سن، جنس و وضعیت ایمنی میزبان می باشد.
بروسلوز یا تب مالت بیماری مشترک بین انسان و دام
دکتر طهرانی درخصوص راههای انتقال این بیماری گفت: بروسلوز یا تب مالت یک بیماری باکتریال مشترک بین انسان و دام
می باشد که در اثر تماس مستقیم و یا غیر مستقیم انسان با حیوانات آلوده یا محصولات لبنی آلوده منتقل می شود.
این عضو هیأت علمی گروه عفونی دانشگاه علوم پزشکی شهید بهشتی، مصرف شیر نجوشیده و غیر پاستوریزه بز، گوسفند و گاو را به عنوان شایعترین راه انتقال بیماری بروسلوز در سراسر جهان ذکر کرد و تاکید کرد: خوردن خامه، بستنی، پنیر و سرشیر تهیه شده از شیر آلوده نیز ریسک بالایی برای انتقال دارد. خوردن گوشت نیم پز یا جگر خام دام آلوده نیز ریسک انتقال دارد ولی چون معمولاً به صورت خام مصرف نمی شود، درصد کمتری از راههای انتقال را شامل می شود. بعضی مشاغل مانند کشاورزان، دامداران، قصاب ها، کارگران کشتارگاه و دامپزشکان؛ به دلیل خطر تماس پوستی مستقیم یا مخاط دام آلوده و فرآورده های دامی آلوده در ریسک بالا برای عفونت بروسلوز هستند. همچنین کارمندان آزمایشگاه به دلیل احتمال استنشاق آئروسل حین کشت دادن این ارگانیسم، بخصوص در كارهایی مثل سانتریفوژ، ریسک ویژه ای برای ابتلا دارند.
تظاهرات بالینی بیماری
دکتر طهرانی ضمن اشاره به وسیع بودن طیف تظاهرات بالینی بیماری، توضیح داد: تظاهرات بالینی در بروسلوز طیف وسیعی دارد از عفونت بدون علامت تا فرمهای حاد، تحت حاد، مزمن و عارضه دار ازجمله اسپوندیلیت، نوروبروسلوزیس، اپیدیموارکیت، اندوکاردیت، هپاتیت، آرتریت و به بیماری هزار چهره معروف است. در فرم حاد، معمولا بیماران در مراحل اولیه از ضعف و خستگی درانجام کارهای روزانه شاکی هستند که بدنبال آن علایم تب و لرز، درد عمومی بدن به خصوص درد پشت و تعریق شدید شبانه، بی اشتهایی و سستی ظاهر میشود. دردهای عضلانی و استخوانی، سر درد، خستگی، بی اشتهایی، لاغری، افسردگی، بزرگ شدن کبد و طحال و بزرگی غدد لنفاوی نیز ازجمله علایم تب مالت به شمار می رود.
راههای پیشگیری از بروسلوز
این متخصص بیماری های عفونی درادامه مهمترین راه های پیشگیری از بیماری را برشمرد و افزود: افزایش آگاهی جامعه از راههای انتقال بیماری به صورت پیشگیری می تواند باعث کاهش موارد ابتلا شود؛ با توجه به اینکه شایع ترین راه انتقال بروسلوز، مصرف شیر و لبنیات آلوده است، بنابراین تغییر عادات غذایی و سالم سازی غذا بسیار مهم است؛ باکتری بروسلا در اثر حرارت مناسب از بین می رود. اندازه مناسب حرارت دادن شیر به اندازه ای است که پس از رسیدن به نقطه جوش، 3 تا 5 دقیقه بجوشد. پنیر، خامه و سرشیر نیز باید از شیر پاستوریزه شده تهیه شود؛ تمام افرادی که پروسیژرهای با ریسک بالا انجام می دهند که تماس با دام یا فرآورده های آن را دارد (مانند کارگران کشتارگاه ها، قصاب ها، دامداران، دامپزشکان و. . . ) باید از وسایل حفاظت شخصی کامل استفاده کنند. این موارد شامل: لباس کار، پیش بند پلاستیکی، کفش مخصوص، ماسک، دستکش و محافظ چشم می باشد؛ همجنین بعد از تماس با محیط آلوده نیز باید شستشوی صحیح دست ها با آب و صابون انجام شود.
دکتر طهرانی درخاتمه ضمن تاکید بر قابل درمان بودن بیماری بروسلوز، تاکید کرد: در صورت بروز علایم فوق، باید هرچه سریعتر به پزشک مراجعه شود.
